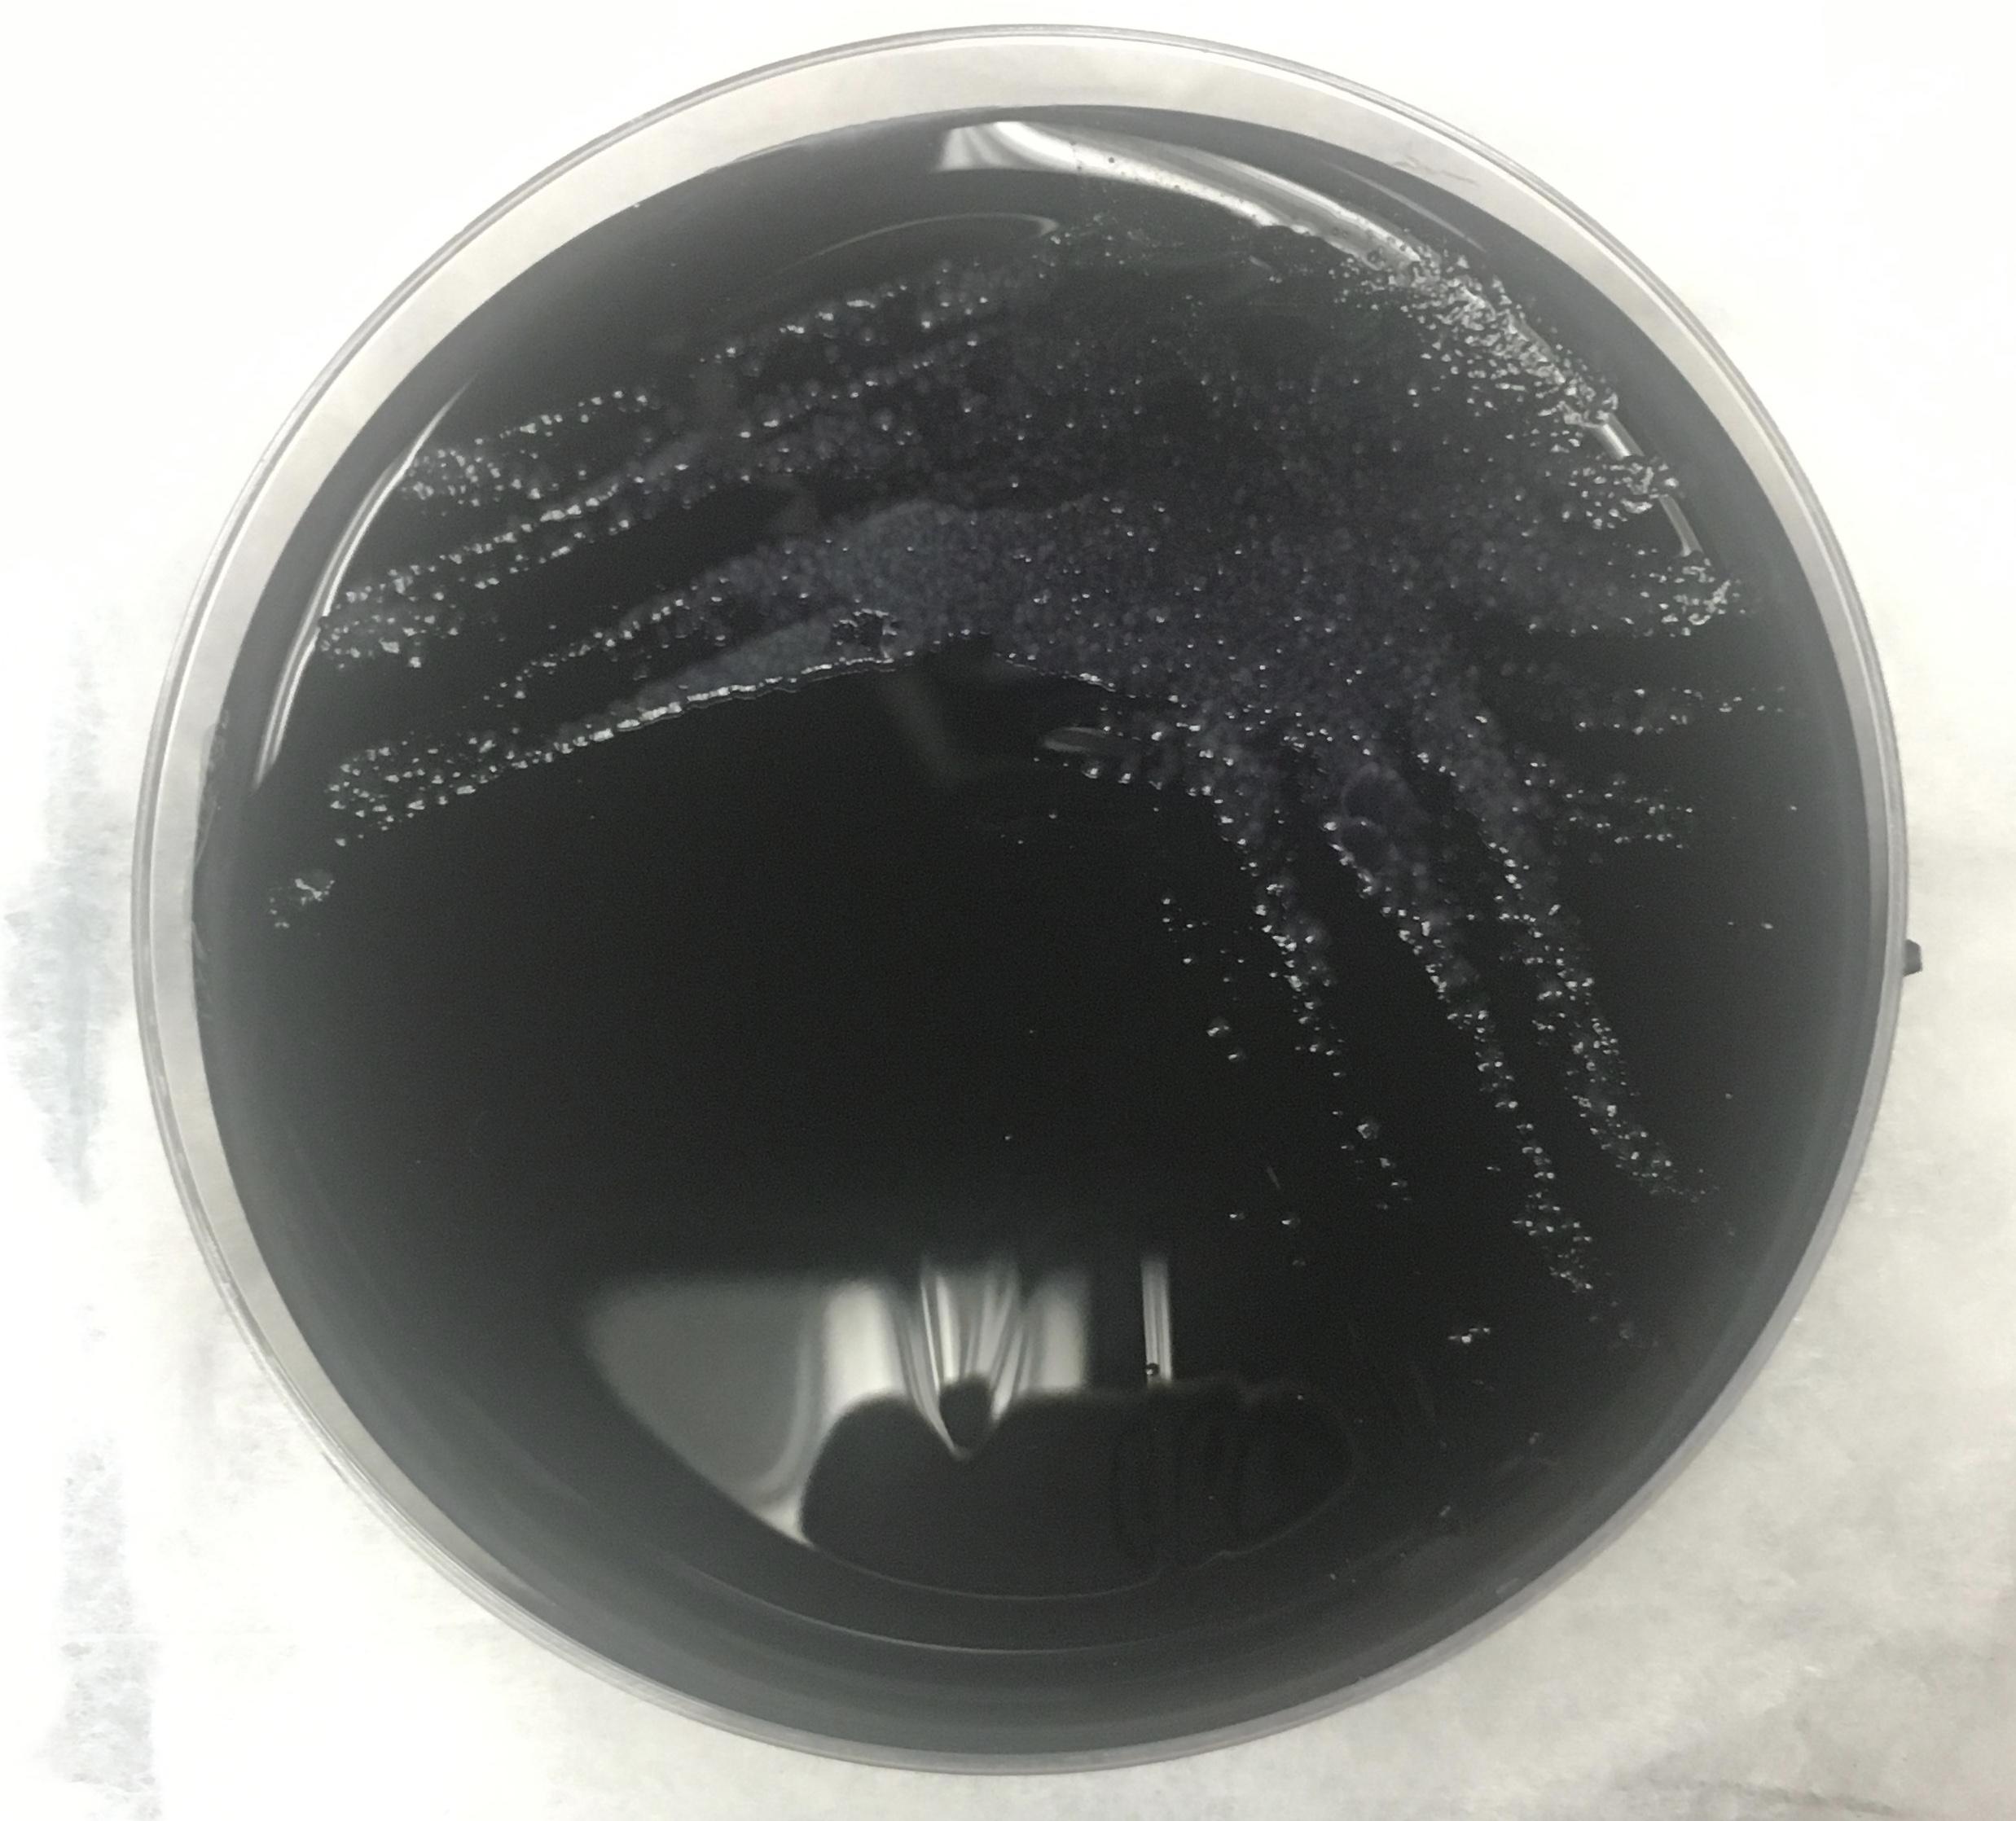
Fig 2a

Peer Reviewed
Legionella Pneumonia Associated With Tumor Necrosis Factor Inhibition
Authors:
Kawthar A. Mohamed
Michigan State University College of Human Medicine, East Lansing, Michigan
Romina Bromberg, MD
Division of Infectious Diseases, University of Connecticut Health Center, Farmington, Connecticut
David Banach, MD, MPH, MS
Division of infectious Diseases, University of Connecticut Health Center, Farmington, Connecticut
Citation:
Mohamed KA, Bromberg R, Banach D. Legionella pneumonia associated with tumor necrosis factor inhibition. Consultant. 2019;59(12):367-370.
A 53-year-old man presented to the emergency department (ED) with a 5-day history of progressively worsening cough, severe headache, myalgias, generalized weakness; a 2-day history of fevers; and new-onset altered mental status.
History. The patient’s history was significant for psoriatic arthritis, diagnosed 10 years prior, that had been treated with the tumor necrosis factor α (TNF-α) inhibitor adalimumab for the past 2 years. Of note, the patient builds displays for museum exhibits, and his occupational responsibilities include regular use of water fogging and misting systems. Additionally, the patient resides in the US Northeast and has frequent outdoor exposure as an avid hiker and biker in wooded regions.
Physical examination. Upon presentation to the ED, his vital signs included a temperature of 39°C, a heart rate of 118 beats/min, a respiratory rate of 18 breaths/min, and oxygen saturation of 89% on room air. Initial examination findings were also notable for confusion and disorientation and dry oral mucosa. Pulmonary examination revealed decreased breath sounds in the right lower lung field. Other than disorientation, the neurological examination findings were normal.
Diagnostic tests. Initial laboratory test results were significant for a low white blood cell count of 3600/µL (41% bands), a low platelet count of 100 × 103/µL, a low sodium level of 129 mEq/L, a high blood urea nitrogen level of 26 mg/dL, a high creatinine level of 1.5 mg/dL, a high aspartate aminotransferase level of 63 U/L, a high total bilirubin level of 6.3 mg/dL, and a high direct bilirubin level of 4.3 mg/dL. In addition to obtaining blood cultures, the initial infectious workup included a respiratory viral and bacterial pathogen panel, influenza direct fluorescent antibody (DFA) testing, and polymerase chain reaction (PCR).
Chest radiographs revealed a dense consolidation in the right lower lobe (Figure 1). Additional imaging included right upper-quadrant ultrasonography, the findings of which were notable for mild intrahepatic dilation and mild biliary sludging. An empiric antibiotic regimen was initiated for community-acquired pneumonia with ceftriaxone, azithromycin, and doxycycline; this regimen subsequently was modified to vancomycin, azithromycin, and cefepime.


Figure 1. Anteroposterior (top) and lateral (bottom) chest radiographs showed an area of focal consolidation in the right middle and lower lung.
Despite the initiation of appropriate breathing treatments and attempts at fluid resuscitation, the patient continued to be tachycardic, hypotensive, and tachypneic and showed signs of impending respiratory collapse, requiring transfer to the intensive care unit (ICU) for emergent intubation and pressure support. He subsequently underwent bronchoscopy.
A bronchoalveolar lavage (BAL) specimen was sent for analysis, including Gram stain and bacterial, viral, and fungal cultures of sputum; given the patient’s epidemiologic risk factors and his use of a TNF-α inhibitor, a high suspicion existed for Legionella infection, a sputum sample was sent for Legionella DFA testing and culture. A urine Legionella antigen test also was ordered.
On day 4 of hospitalization, the BAL sample was found to be Legionella-positive via DFA testing; sputum cultures eventually grew Legionella pneumophila (Figure 2). Accordingly, the patient’s antibiotic regimen was deescalated to azithromycin monotherapy. However, despite targeted therapy, the patient continued to experience significant respiratory compromise.

Figure 2. Detection of L pneumophila organisms from a sputum sample obtained from BAL. Top: Visualization of L pneumophila cultured on charcoal yeast extract. Middle: L pneumophila visualized on Gram stain. Bottom L pneumophila visualized on DFA staining.
Computed tomography (CT) scans of the chest revealed continued right lower-lobe consolidation and a moderate right-sided pleural effusion (Figure 3). The patient subsequently underwent chest-tube placement, and his clinical status improved; following successful extubation, he was transferred out of the ICU.


Figure 3. CT scans of chest demonstrated a focal area of consolidation in the right middle and lower lobes (top) and moderate right-sided pleural effusion (bottom).
Outcome of the case. At the time of discharge, the patient was afebrile, with resolution of hypotension and an oxygen saturation of 92% on room air. Laboratory study results showed improvement of his abnormal liver enzymes that had been noted on presentation, and markers of infection were within normal limits. He clinically recovered and was discharged to complete a 2-week course of oral azithromycin with scheduled outpatient follow-up for assessment of disease resolution.
Discussion. Legionnaires disease (LD), or pneumonia secondary to L pneumophila infection, is an important cause of community-acquired pneumonia, particularly in the setting of certain epidemiological risk factors, such as patients who present with clinical signs of pneumonia following a known outbreak and/or known contact with contaminated bodies of water.
L pneumophila is a gram-negative facultative intracellular anaerobe that is endemic to larger bodies of water such as lakes and streams, as well as reservoirs of water associated with fogging and misting systems. Transmission to humans occurs following the inhalation of aerosolized particles derived from these contaminated water sources.
In 1976, following an outbreak of pneumonia during a convention of the American Legion in Philadelphia, it was determined that transmission of the disease is from inhalation of particles in the environment rather than from person to person contact. The following year, McDade and colleagues identified the causative agent as a waterborne pathogen following isolation of the bacterium from air-conditioner cooling systems.1 Since then, other communitywide outbreaks of L pneumophila infection reported in the literature have occurred in the setting of exposure to various sources of contaminated water, including aerosol-producing devices2—which was the likely etiology of LD in our patient’s case, given his occupational exposure to water fogging and misting systems.
Upon inhalation, L pneumophila travels to dependent areas of the lung—in particular the alveolar macrophages—and has a typical incubation period of up to 2 weeks. Following transmission, L pneumophila infection can result in LD—ie, Legionella pneumonia or Pontiac fever, a less-severe self-limiting febrile illness. Clinically, Legionella pneumonia presents similarly to other forms of pneumonia with a prodrome of flulike symptoms including fever, chills, and myalgias, followed by productive cough, dyspnea, and a severe headache. Although disease progression is variable, signs of decompensation include persistent fevers, worsening tachycardia, tachypnea, accessory muscle use, and signs of respiratory fatigue despite appropriate medical management.3 As evidenced in our case, patients can decompensate rapidly without appropriate intervention and can develop acute hypoxemic respiratory failure requiring emergent airway management.
LD is noted to follow an atypical pattern of pneumonia, with clinical features preceding the radiographic manifestations of the disease process. Chest radiography findings of Legionnaires are nondiagnostic and can include multifocal or localized lung involvement with or without the presence of diffuse pulmonary infiltrates and pleural effusions,4 as we saw in our patient. Features that can distinguish LD from other types of pneumonia include laboratory findings of multisystem involvement, such as the transaminitis and hyponatremia seen in our patient. Additionally, treatment failure with broad-spectrum antibiotics that do not include a macrolide or a respiratory fluoroquinolone raises a high clinical suspicion for Legionella pneumonia.
Establishing a diagnosis of Legionella pneumonia usually requires a high clinical suspicion for infection and ruling out of other potential causes of pneumonia. The initial diagnostic workup is done with urine antigen testing for L pneumophila serogroup 1, the serogroup that is most often responsible for Legionella pneumonia. However, although its presence in the urine is confirmatory, a negative test does not rule out Legionella, given that several other Legionella species and serogroups are associated with LD.5 Therefore, if a high clinical suspicion for Legionella is present—particularly in a critically ill patient and/or a worsening patient who is unresponsive to interventions, as in our patient’s case—additional diagnostic testing must be undertaken with Gram stain and culture of sputum from lower respiratory tract secretions obtained following BAL.3
Of note, given the pathogenesis of L pneumophila, the use of TNF-α inhibitors such as adalimumab potentiates an increased risk of Legionella infection, poorer outcome, and slower return to a baseline level of health following initiation of appropriate antibiotics and respiratory support treatment interventions.6 TNF-α is a protein produced by lymphoid cells including alveolar macrophages, and it is involved in a variety of cell-signaling pathways by acting as an important mediator of host response to infections. In the setting of an infection with an intracellular pathogen such as Legionella, TNF-α functions to impair the replication of the organism inside the phagosome.7 Therefore, inhibition of this cytokine, as seen in our patient’s case, facilitates replication of the pathogen, potentiating the development of respiratory failure and circulatory collapse in addition to extrapulmonary findings such as altered mentation and acute liver injury.8
This case highlights the importance of diagnostic testing for Legionella and the initiation of empiric antibiotic therapy with activity against it among patients with host-related factors and potential environmental exposure to this organism.
- McDade JE, Shepard CC, Fraser DW, Tsai TR, Redus MA, Dowdle WR; Laboratory Investigation Team. Legionnaires’ disease—isolation of a bacterium and demonstration of its role in other respiratory disease. N Engl J Med. 1977;297(22):1197-1203.
- Woo AH, Goetz A, Yu VL. Transmission of Legionella by respiratory equipment and aerosol generating devices. Chest. 1992;102(5):1586-1590.
- Fields BS, Benson RF, Besser RE. Legionella and Legionnaires’ disease: 25 years of investigation. Clin Microbiol Rev. 2002;15(3):506-526.
- Cunha BA. Legionnaires’ disease: clinical differentiation from typical and other atypical pneumonias. Infect Dis Clin North Am. 2010;24(1):73-105.
- Pierre DM, Baron J, Yu VL, Stout JE. Diagnostic testing for Legionnaires’ disease. Ann Clin Microbiol Antimicrob. 2017;16(1):59.
- Lanternier F, Tubach F, Ravaud P, et al; Research Axed on Tolerance of Biotherapies Group. Incidence and risk factors of Legionella pneumophila pneumonia during anti-tumor necrosis factor therapy: a prospective French study. Chest. 2013;144(3):990-998.
- Skerrett SJ, Bagby GJ, Schmidt RA, Nelson S. Antibody-mediated depletion of tumor necrosis factor-α impairs pulmonary host defenses to Legionella pneumophila. J Infect Dis. 1997;176(4):1019-1028.
- Ziltener P, Reinheckel T, Oxenius A. Neutrophil and alveolar macrophage-mediated innate immune control of Legionella pneumophila lung infection via TNF and ROS. PLoS Pathog. 2016;12(4):e1005591.


